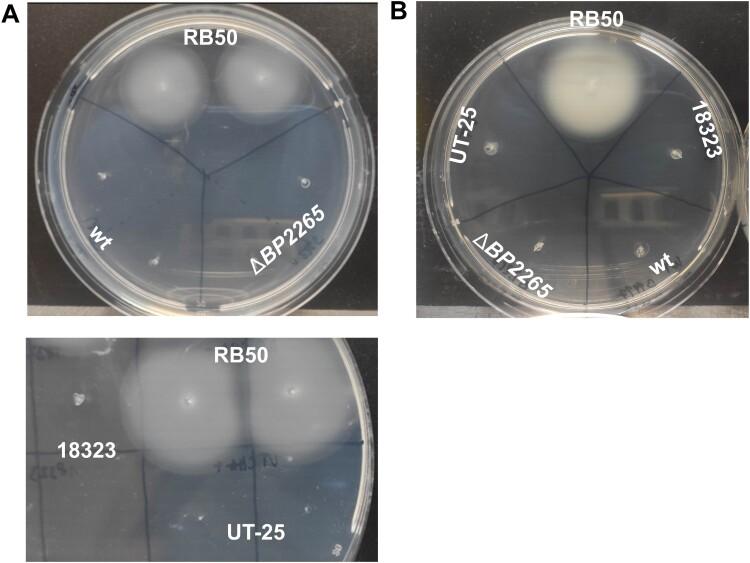
https://cdn.ncbi.nlm.nih.gov/pmc/blobs/1f3b/10732220/5acb0d343539/TEMI_A_2272638_F0004_OC.jpg

CesT 家族的 T3SS 伴侣蛋白是抗σ因子 BtrA 在. 分泌所必需的。
T3SS chaperone of the CesT family is required for secretion of the anti-sigma factor BtrA in .
机构信息
Laboratory of post-transcriptional control of gene expression, Institute of Microbiology of the Czech Academy of Sciences, Prague, Czech Republic.
出版信息
Emerg Microbes Infect. 2023 Dec;12(2):2272638. doi: 10.1080/22221751.2023.2272638. Epub 2023 Nov 1.
is a Gram-negative, strictly human re-emerging respiratory pathogen and the causative agent of whooping cough. Similar to other Gram-negative pathogens, produces the type III secretion system, but its role in the pathogenesis of is enigmatic and yet to be elucidated. Here, we combined RNA-seq, LC-MS/MS, and co-immunoprecipitation techniques to identify and characterize the novel CesT family T3SS chaperone BP2265. We show that this chaperone specifically interacts with the secreted T3SS regulator BtrA and represents the first non-flagellar chaperone required for the secretion of an anti-sigma factor. In its absence, secretion but not production of BtrA and most T3SS substrates is severely impaired. It appears that the role of BtrA in regulating T3SS extends beyond its activity as an antagonist of the sigma factor BtrS. Predictions made by artificial intelligence system AlphaFold support the chaperone function of BP2265 towards BtrA and outline the structural basis for the interaction of BtrA with its target BtrS. We propose to rename BP2265 to BtcB for the type III chaperone of BtrA.In addition, the absence of the BtcB chaperone results in increased expression of numerous flagellar genes and several virulence genes. While increased production of flagellar proteins and intimin BipA translated into increased biofilm formation by the mutant, enhanced production of virulence factors resulted in increased cytotoxicity towards human macrophages. We hypothesize that these phenotypic traits result indirectly from impaired secretion of BtrA and altered activity of the BtrA/BtrS regulatory node.
是一种革兰氏阴性、严格的人呼吸道再发病原体,也是百日咳的病原体。与其他革兰氏阴性病原体相似,产生 III 型分泌系统,但它在 的发病机制中的作用仍然神秘莫测,尚未阐明。在这里,我们结合 RNA-seq、LC-MS/MS 和共免疫沉淀技术,鉴定和描述了新型 CesT 家族 T3SS 伴侣 BP2265。我们表明,这种伴侣蛋白特异性地与分泌 T3SS 调节剂 BtrA 相互作用,代表了第一个非鞭毛伴侣蛋白,是分泌抗 sigma 因子所必需的。在没有它的情况下,BtrA 的分泌而不是产生以及大多数 T3SS 底物的分泌严重受损。似乎 BtrA 在调节 T3SS 中的作用超出了其作为 sigma 因子 BtrS 的拮抗剂的活性。人工智能系统 AlphaFold 的预测支持 BP2265 对 BtrA 的伴侣功能,并概述了 BtrA 与其靶标 BtrS 相互作用的结构基础。我们建议将 BP2265 重新命名为 BtrA 的 III 型伴侣蛋白 BtcB。此外,缺乏 BtcB 伴侣蛋白会导致许多鞭毛基因和几种毒力基因的表达增加。虽然鞭毛蛋白和 BipA 的增加产生了突变体生物膜形成的增加,但毒力因子的增加产生了对人巨噬细胞的增加的细胞毒性。我们假设这些表型特征间接源自 BtrA 分泌受损和 BtrA/BtrS 调节节点活性改变。